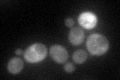
YJR137C
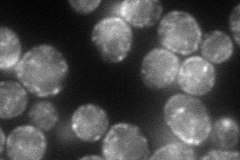
YJR137C
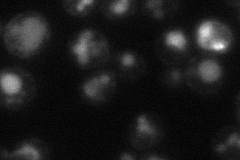
YJR137C
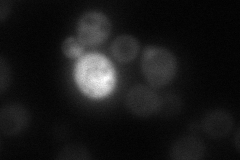
YJR137C
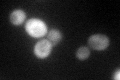
YJR137C
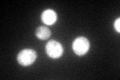
YJR137C

View description
Sulfite reductase beta subunit, involved in amino acid biosynthesis, transcription repressed by methionine
Localization:
Intensity:
Fold change:
Significance:
-
C’ GFP library in SD
cytosol58.5 -
N' NOP1pr-GFP in SD
cell periphery,punctate,vacuole81.7491 -
N' TEF2pr-mCherry in SD
cell periphery,vacuole23.794 -
N' NATIVEpr-GFP in SD
cytosol33.4873 -
N' TEF2pr-VC and Cyto-VN in SD

#N/A0 -
C’ GFP library in SD+DTT

cytosol79.191.35Yes -
C’ GFP library in SD+H2O2
cytosol100.991.72Yes -
C’ GFP library in Starvation Media
cytosol275.254.7Yes -
C’ GFP library on the background of Pup2-DaMP

cytosol -
C’ GFP library on the background of CCT mutant

cytosol58.08260.992753No
